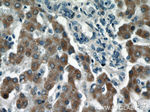
LRRC41 Antibody in Immunohistochemistry (Paraffin) (IHC (P))

Search
Proteintech
LRRC41 Polyclonal Antibody
{{$productOrderCtrl.translations['antibody.pdp.commerceCard.promotion.promotions']}}
{{$productOrderCtrl.translations['antibody.pdp.commerceCard.promotion.viewpromo']}}
{{$productOrderCtrl.translations['antibody.pdp.commerceCard.promotion.promocode']}}: {{promo.promoCode}} {{promo.promoTitle}} {{promo.promoDescription}}. {{$productOrderCtrl.translations['antibody.pdp.commerceCard.promotion.learnmore']}}
产品信息
20457-1-AP
种属反应
宿主/亚型
分类
类型
抗原
偶联物
形式
浓度
规格
纯化类型
保存液
内含物
保存条件
运输条件
产品详细信息
Immunogen sequence: STLELFTVP LSTEAALTLC HLLSSWVSLE SLTLSYNGLG SNIFRLLDSL RALSGQAGCR LRALHLSDLF SPLPILELTR AIVRALPLLR VLSIRVDHPS QRDNPGVPGN AGPPSHIIGD EEIPENCLEQ LEMGFPRGAQ PAPLLCSVLK ASGSLQQLSL DSATFASPQD FGLVLQTLKE YNLALKRLSF HDMNLADCQS EVLFLLQNLT LQEITFSFCR LFEKRPAQFL PEMVAAMKGN STLKGLRLPG NRLGNAGLLA LADVFSEDSS SSLCQLDISS NCIKPDGLLE FAKRLERWGR GAFGHLRLFQ NWLDQDAVTA REAIRRLRAT CHVVSDSWDS SQAFADYVST M (463-812 aa encoded by BC004953)
靶标信息
Probable substrate recognition component of an ECS (Elongin BC-CUL2/5-SOCS-box protein) E3 ubiquitin ligase complex which mediates the ubiquitination and subsequent proteasomal degradation of target proteins. [UniProt]
仅用于科研。不用于诊断过程。未经明确授权不得转售。
篇参考文献 (0)
生物信息学
蛋白别名: elongin BC-interacting leucine-rich repeat protein; Leucine-rich repeat-containing protein 41; muf1; MUF1 protein; MUF1 protein (MUF1); Protein Muf1; RP4-636H5.2; unnamed protein product
基因别名: AA409966; AW555107; D630045E04Rik; D730026A16Rik; LRRC41; MUF1; PP7759; RGD1311221
UniProt ID: (Human) Q15345, (Mouse) Q8K1C9, (Rat) Q5M9H1
Entrez Gene ID: (Human) 10489, (Mouse) 230654, (Rat) 362566